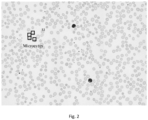
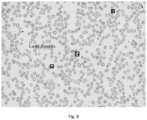

EP4257984A1 - Probenanalysesystem und -verfahren, probenbildanalysesystem und blutanalysegerät - Google Patents
Probenanalysesystem und -verfahren, probenbildanalysesystem und blutanalysegerät Download PDFInfo
- Publication number
- EP4257984A1 EP4257984A1 EP20963958.2A EP20963958A EP4257984A1 EP 4257984 A1 EP4257984 A1 EP 4257984A1 EP 20963958 A EP20963958 A EP 20963958A EP 4257984 A1 EP4257984 A1 EP 4257984A1
- Authority
- EP
- European Patent Office
- Prior art keywords
- sample
- test
- instruction
- test blood
- hematology analyzer
- Prior art date
- Legal status (The legal status is an assumption and is not a legal conclusion. Google has not performed a legal analysis and makes no representation as to the accuracy of the status listed.)
- Granted
Links
Images
Classifications
-
- G—PHYSICS
- G01—MEASURING; TESTING
- G01N—INVESTIGATING OR ANALYSING MATERIALS BY DETERMINING THEIR CHEMICAL OR PHYSICAL PROPERTIES
- G01N15/00—Investigating characteristics of particles; Investigating permeability, pore-volume or surface-area of porous materials
- G01N15/02—Investigating particle size or size distribution
- G01N15/0205—Investigating particle size or size distribution by optical means
- G01N15/0227—Investigating particle size or size distribution by optical means using imaging; using holography
-
- G—PHYSICS
- G01—MEASURING; TESTING
- G01N—INVESTIGATING OR ANALYSING MATERIALS BY DETERMINING THEIR CHEMICAL OR PHYSICAL PROPERTIES
- G01N15/00—Investigating characteristics of particles; Investigating permeability, pore-volume or surface-area of porous materials
- G01N15/10—Investigating individual particles
- G01N15/14—Optical investigation techniques, e.g. flow cytometry
- G01N15/1429—Signal processing
- G01N15/1433—Signal processing using image recognition
-
- G—PHYSICS
- G01—MEASURING; TESTING
- G01N—INVESTIGATING OR ANALYSING MATERIALS BY DETERMINING THEIR CHEMICAL OR PHYSICAL PROPERTIES
- G01N15/00—Investigating characteristics of particles; Investigating permeability, pore-volume or surface-area of porous materials
- G01N15/10—Investigating individual particles
-
- G—PHYSICS
- G01—MEASURING; TESTING
- G01N—INVESTIGATING OR ANALYSING MATERIALS BY DETERMINING THEIR CHEMICAL OR PHYSICAL PROPERTIES
- G01N15/00—Investigating characteristics of particles; Investigating permeability, pore-volume or surface-area of porous materials
- G01N15/10—Investigating individual particles
- G01N15/14—Optical investigation techniques, e.g. flow cytometry
- G01N15/1429—Signal processing
-
- G—PHYSICS
- G01—MEASURING; TESTING
- G01N—INVESTIGATING OR ANALYSING MATERIALS BY DETERMINING THEIR CHEMICAL OR PHYSICAL PROPERTIES
- G01N35/00—Automatic analysis not limited to methods or materials provided for in any single one of groups G01N1/00 - G01N33/00; Handling materials therefor
- G01N35/00029—Automatic analysis not limited to methods or materials provided for in any single one of groups G01N1/00 - G01N33/00; Handling materials therefor provided with flat sample substrates, e.g. slides
-
- G—PHYSICS
- G01—MEASURING; TESTING
- G01N—INVESTIGATING OR ANALYSING MATERIALS BY DETERMINING THEIR CHEMICAL OR PHYSICAL PROPERTIES
- G01N35/00—Automatic analysis not limited to methods or materials provided for in any single one of groups G01N1/00 - G01N33/00; Handling materials therefor
- G01N35/00584—Control arrangements for automatic analysers
- G01N35/00594—Quality control, including calibration or testing of components of the analyser
- G01N35/00603—Reinspection of samples
-
- G—PHYSICS
- G01—MEASURING; TESTING
- G01N—INVESTIGATING OR ANALYSING MATERIALS BY DETERMINING THEIR CHEMICAL OR PHYSICAL PROPERTIES
- G01N15/00—Investigating characteristics of particles; Investigating permeability, pore-volume or surface-area of porous materials
- G01N15/01—Investigating characteristics of particles; Investigating permeability, pore-volume or surface-area of porous materials specially adapted for biological cells, e.g. blood cells
-
- G—PHYSICS
- G01—MEASURING; TESTING
- G01N—INVESTIGATING OR ANALYSING MATERIALS BY DETERMINING THEIR CHEMICAL OR PHYSICAL PROPERTIES
- G01N15/00—Investigating characteristics of particles; Investigating permeability, pore-volume or surface-area of porous materials
- G01N2015/0092—Monitoring flocculation or agglomeration
-
- G—PHYSICS
- G01—MEASURING; TESTING
- G01N—INVESTIGATING OR ANALYSING MATERIALS BY DETERMINING THEIR CHEMICAL OR PHYSICAL PROPERTIES
- G01N15/00—Investigating characteristics of particles; Investigating permeability, pore-volume or surface-area of porous materials
- G01N15/01—Investigating characteristics of particles; Investigating permeability, pore-volume or surface-area of porous materials specially adapted for biological cells, e.g. blood cells
- G01N2015/012—Red blood cells
-
- G—PHYSICS
- G01—MEASURING; TESTING
- G01N—INVESTIGATING OR ANALYSING MATERIALS BY DETERMINING THEIR CHEMICAL OR PHYSICAL PROPERTIES
- G01N15/00—Investigating characteristics of particles; Investigating permeability, pore-volume or surface-area of porous materials
- G01N15/01—Investigating characteristics of particles; Investigating permeability, pore-volume or surface-area of porous materials specially adapted for biological cells, e.g. blood cells
- G01N2015/016—White blood cells
-
- G—PHYSICS
- G01—MEASURING; TESTING
- G01N—INVESTIGATING OR ANALYSING MATERIALS BY DETERMINING THEIR CHEMICAL OR PHYSICAL PROPERTIES
- G01N15/00—Investigating characteristics of particles; Investigating permeability, pore-volume or surface-area of porous materials
- G01N15/01—Investigating characteristics of particles; Investigating permeability, pore-volume or surface-area of porous materials specially adapted for biological cells, e.g. blood cells
- G01N2015/018—Platelets
-
- G—PHYSICS
- G01—MEASURING; TESTING
- G01N—INVESTIGATING OR ANALYSING MATERIALS BY DETERMINING THEIR CHEMICAL OR PHYSICAL PROPERTIES
- G01N15/00—Investigating characteristics of particles; Investigating permeability, pore-volume or surface-area of porous materials
- G01N15/10—Investigating individual particles
- G01N2015/1006—Investigating individual particles for cytology
-
- G—PHYSICS
- G01—MEASURING; TESTING
- G01N—INVESTIGATING OR ANALYSING MATERIALS BY DETERMINING THEIR CHEMICAL OR PHYSICAL PROPERTIES
- G01N15/00—Investigating characteristics of particles; Investigating permeability, pore-volume or surface-area of porous materials
- G01N15/10—Investigating individual particles
- G01N15/14—Optical investigation techniques, e.g. flow cytometry
- G01N2015/1402—Data analysis by thresholding or gating operations performed on the acquired signals or stored data
Definitions
- the disclosure relates to the field of sample analysis technologies, and more specifically to a sample analysis system and method, a sample image analysis system, and a hematology analyzer.
- a procedure of a clinical laboratory is generally as follows: testing samples using a blood cell analyzer; performing slide smearing and staining for a sample that triggers retest rules pre-formulated by the laboratory; and performing morphological examination on a blood smear, and outputting an examination result.
- a sample analysis system includes at least one hematology analyzer, a controller, a first transport apparatus, a sample slide preparation apparatus, and a sample image capturing apparatus, wherein one of the hematology analyzers is configured to analyze a first test blood sample of a subject to obtain a sample analysis result; the controller is configured to control the first transport apparatus to transport the first test blood sample to the sample slide preparation apparatus, when the sample analysis result satisfies a preset condition; the sample slide preparation apparatus is configured to prepare a sample slide of the first test blood sample; the sample image capturing apparatus is configured to capture a sample image of a sample region on the sample slide; and the controller is further configured to generate a retest instruction and send the retest instruction to one of the hematology analyzers, so that said hematology analyzer retests a second test blood sample of the subject, when the sample image contains information indicating that the first test blood sample is an abnormal sample.
- a sample analysis system in another aspect of the disclosure, includes a sample image capturing apparatus, a controller and a hematology analyzer, wherein the sample image capturing apparatus is configured to capture a sample image of a sample region on a sample slide, the sample slide being prepared from a first test blood sample of a subject; the controller is configured to generate a test instruction and send the test instruction to the hematology analyzer, so that the hematology analyzer analyzes a second test blood sample of the subject, when the sample image contains information indicating that the first test blood sample is an abnormal sample; and the hematology analyzer is configured to analyze the second test blood sample, so as to obtain a sample analysis result.
- a sample analysis method includes: obtaining a sample analysis result of a first test blood sample of a subject; obtaining a sample image of a sample region on a sample slide of the first test blood sample, when the sample analysis result satisfies a preset condition; and analyzing the sample image, and generating a retest instruction and sending the retest instruction to a hematology analyzer, so that the hematology analyzer retests a second test blood sample of the subject, when the sample image contains information indicating that the first test blood sample is an abnormal sample.
- a sample analysis method includes: obtaining a sample analysis result of a first test blood sample of a subject; obtaining a sample image of a sample region on a sample slide of the first test blood sample, when the sample analysis result satisfies a preset condition; and analyzing the sample image, and generating a retest instruction and sending the retest instruction to a hematology analyzer, so that the hematology analyzer retests a second test blood sample of same subject, when the sample image contains information indicating that the first test blood sample is an abnormal sample.
- a sample image analysis system includes a sample image capturing apparatus and a controller, wherein the sample image capturing apparatus is configured to capture a sample image of a sample region on a sample slide prepared from a first test blood sample of a subject; and the controller is configured to analyze the sample image, and generate an instruction that causes a hematology analyzer to test a second test blood sample of the subject, when it is determined that the first test blood sample is an abnormal sample based on the cell image.
- a hematology analyzer includes a sampling apparatus, a sample preparation apparatus, a test apparatus and a controller, wherein the controller is configured to receive retest information associated with a sample slide that is sent by a sample image capturing apparatus or an instrument communicatively connected to the sample image capturing apparatus, and control the sampling apparatus, the sample preparation apparatus, and the test apparatus to analyze a second test blood sample of a subject based on the received retest information,, the sample slide being prepared from a first test blood sample of the subject; the sampling apparatus is configured to sample the second test blood sample from a sample container; the sample preparation apparatus is configured to mix the second test blood sample and a reagent to prepare a blood sample solution; and the test apparatus is configured to test the blood sample solution to obtain a blood routine test parameter.
- the retest instruction or test instruction is generated when the sample image of the blood sample contains information indicating that the sample is an abnormal sample, such that the hematology analyzer retests or tests the blood sample of the same subject according to the instruction, thereby realizing controlling the hematology analyzer based on the sample image; and because the sample image of the abnormal sample contains abnormal sample information, the hematology analyzer can be controlled to perform a specific retest or test operation based on the abnormal sample information, and a more accurate test result can thus be obtained.
- FIG. 1 is a schematic flowchart of a sample analysis system 100 according to an embodiment of the disclosure.
- the sample analysis system 100 includes one or more hematology analyzers 110, a controller 120, a first transport apparatus 130, a sample slide preparation apparatus 140, and a sample image capturing apparatus 150.
- One of the hematology analyzers 110 is configured to analyze a first test blood sample of a subject to obtain a sample analysis result (for example, a blood routine test result).
- the controller 120 is configured to control the first transport apparatus 130 to transport the first test blood sample to the sample slide preparation apparatus 140, when the sample analysis result satisfies a preset condition.
- the sample slide preparation apparatus 140 is configured to prepare a sample slide of the first test blood sample.
- the sample image capturing apparatus 150 is configured to capture a sample image of a sample region on the sample slide.
- the controller 120 is further configured to generate a retest instruction and send the retest instruction to one of the hematology analyzers 110, so that said hematology analyzer retests a second test blood sample of the subject, when the sample image contains information indicating that the first test blood sample is an abnormal sample.
- said hematology analyzer configured for the retest (that is, analyzing the second test blood sample) and the hematology analyzer configured for the initial test (that is, analyzing the first test blood sample) may be a same hematology analyzer or different hematology analyzers.
- both the second test blood sample and the first test blood sample are blood samples of the same subject, and may be from a same sample container or different sample containers.
- the sample image of the blood sample that satisfies the preset condition is captured by the sample image capturing apparatus 150 (for example, the sample slide is transported by a second transport apparatus or manually from the sample slide preparation apparatus 140 to the sample image capturing apparatus 150 so as to capture the sample image), and when the sample image contains information indicating that the blood sample is an abnormal sample (wherein the sample image may be analyzed by the sample image capturing apparatus 150 or by the controller 120 or manually, so as to determine whether the sample image contains information indicating that the blood sample is an abnormal sample), a hematology analyzer 110 is triggered to retest a blood sample of the same subject (wherein the blood sample to be retested may be transported by a third transport apparatus or manually to said hematology analyzer).
- the sample image capturing apparatus 150 for example, the sample slide is transported by a second transport apparatus or manually from the sample slide preparation apparatus 140 to the sample image capturing apparatus 150 so as to capture the sample image
- the sample image contains information indicating that the blood sample is an abnormal sample
- the operation of said hematology analyzer can be controlled based on the sample image, and because the sample image of the abnormal sample contains abnormal sample information, said hematology analyzer can be controlled to perform a specific retest or test operation based on the abnormal sample information, and a more accurate test result can thus be obtained.
- the controller 120 may be further configured to: determine an abnormality type of the first test blood sample based on the sample image, and generate the retest instruction based on the abnormality type, wherein the retest instruction includes an instruction that causes said hematology analyzer to perform the retest under a test condition corresponding to the abnormality type of the blood sample.
- said hematology analyzer performs the retest under the test condition corresponding to the abnormality type of the blood sample, and can implement the retest in a targeted manner, thereby outputting a more accurate test result.
- the hematology analyzer analyzes the first test blood sample under a first test condition, and retests the second test blood sample under a second test condition, wherein the second test condition is different from the first test condition.
- the test conditions under which the hematology analyzer performs the initial test and the retest on the blood samples of the same subject may be different, the test condition for the retest depends on the abnormality type of the corresponding blood sample, and thus whether the blood sample of the subject is abnormal and a specific test result (for example, a quantitative numerical result) can certainly be determined based on the retest result.
- a specific test result for example, a quantitative numerical result
- FIG. 2 is an exemplary schematic diagram showing a sample image of a blood sample containing microcytes.
- the controller 120 may be further configured to generate the retest instruction that causes said hematology analyzer 110 to analyze the second test blood sample by using an optical method (the analysis herein may be referred to as platelet analysis, and because a platelet count value is high due to microcytes that may be mistaken for platelets, the platelets are retested by using the optical method).
- the analysis herein may be referred to as platelet analysis, and because a platelet count value is high due to microcytes that may be mistaken for platelets, the platelets are retested by using the optical method.
- retest results are shown as particle scattergrams in FIG.
- FIG. 4A is the scattergram of reticulocytes
- FIG. 4B is the scattergram of platelets.
- retest results of an optical channel of said hematology analyzer 110 a platelet test result of the blood sample of the subject is normal, while initial test results, such as initial test results of an impedance channel in FIG. 3A and FIG. 3B show a high platelet count.
- the hematology analyzer 110 analyzes the first test blood sample by using the impedance channel (that is, the first test condition), and retests the second test blood sample by using the optical channel (that is, the second test condition), wherein the platelet test result is corrected by the retest, and an accurate platelet count result can be obtained.
- FIG. 5 is an exemplary schematic diagram showing a sample image of a blood sample containing erythrocyte fragments.
- the controller 120 may be further configured to generate the retest instruction that causes said hematology analyzer 110 to analyze the second test blood sample, by using an optical method (the analysis herein may be referred to as platelet analysis, and because a platelet count value is high due to erythrocyte fragments that may be mistaken for platelets, the platelets are retested by using the optical method).
- retest results are shown as particle scattergrams in FIG. 7A and FIG. 7B , wherein FIG. 7A is the scattergram of reticulocytes, and FIG. 7B is the scattergram of platelets.
- a platelet test result of the blood sample of the subject is normal, while initial test results, such as initial test results of the impedance channel in FIG. 6A and FIG. 6B show a high platelet count.
- the hematology analyzer 110 analyzes the first test blood sample by using the impedance channel (that is, the first test condition), and retests the second test blood sample by using the optical channel (that is, the second test condition), wherein the platelet test result is corrected by the retest, and an accurate platelet count result can be obtained.
- FIG. 8 is an exemplary schematic diagram showing a sample image of a blood sample containing large platelets.
- the controller 120 may be further configured to generate the retest instruction that causes said hematology analyzer 110 to analyze the second test blood sample by using the optical method (the analysis herein may be referred to as platelet analysis, and because a platelet count value is low due to large platelets that may be mistaken for erythrocytes, the platelets are retested by using the optical method).
- the retest results are shown as particle scattergrams in FIG.
- FIG. 10A is the scattergram of reticulocytes
- FIG. 10B is the scattergram of platelets.
- a platelet test result of the blood sample of the subject is normal, while initial test results, such as initial test results of the impedance channel in FIG. 9A and FIG. 9B show a low platelet count.
- the hematology analyzer 110 analyzes the first test blood sample by using the impedance channel (that is, the first test condition), and retests the second test blood sample by using the optical channel (that is, the second test condition), wherein the platelet test result is corrected by the retest, and an accurate platelet count result can be obtained.
- the controller 120 may be further configured to generate the retest instruction that causes said hematology analyzer 110 to analyze the second test blood sample by using an optical method, when it is determined, based on the sample image, that the first test blood sample is at least one of a sample having a low platelet value, a sample having platelet aggregation, and a sample having leukocyte fragments.
- This embodiment is similar to the examples described above with reference to FIGS. 2 to 10B , the initial test results may be inaccurate due to interference caused by various reasons, and the retest results may correct the initial test results.
- the controller 120 may be further configured to generate the retest instruction that causes said hematology analyzer 110 to treat the second test blood sample with a platelet disaggregation reagent, when it is determined, based on the sample image, that the first test blood sample is a sample having a low platelet value or a sample having platelet aggregation.
- the platelet disaggregation reagent is a reagent capable of inhibiting platelet aggregation. It is difficult to obtain an accurate platelet count result of the platelet aggregation sample due to platelet aggregation, and a low platelet count result may also be obtained for a sample having a low platelet value due to platelet aggregation. Therefore, in this embodiment, the second test blood sample may be treated with the platelet disaggregation reagent and then tested by using the optical method or the impedance method to obtain an accurate test result.
- the controller 120 may be further configured to generate the retest instruction that causes said hematology analyzer 110 to analyze erythrocytes in the second test blood sample by using an optical method, when it is determined, based on the sample image, that the first test blood sample is a sample having erythrocyte aggregation.
- the blood sample is a sample having erythrocyte aggregation, it indicates that erythrocyte aggregation occurs in the blood sample, which will affect the counting accuracy of erythrocytes. Therefore, in this embodiment, the blood sample is retested by using the optical method that is not affected by the aggregation, so that an accurate erythrocyte count result can be obtained.
- the controller 120 may be further configured to generate the retest instruction that causes the hematology analyzer 110 to analyze hemoglobin in the second test blood sample by using an optical method, when it is determined, based on the sample image, that the first test blood sample is a sample having a falsely elevated hemoglobin.
- the blood sample is a sample having a falsely elevated hemoglobin, it indicates that there is chylous blood in the blood sample, which will affect the determination of a hemoglobin value. Therefore, in this embodiment, the blood sample is retested by using the optical method that is not affected by chylous blood, so that an accurate hemoglobin value can be obtained.
- the controller 120 may be further configured to generate the retest instruction that causes said hematology analyzer 110 to count leukocytes in the second test blood sample by using a leukocyte differential channel, when it is determined, based on the sample image, that the first test blood sample is a sample having leukocyte aggregation.
- a leukocyte differential channel When the blood sample is a sample having leukocyte aggregation, it indicates that leukocyte aggregation occurs in the blood sample. In this case, the counting accuracy of leukocytes is affected if a complete blood count channel (CBC channel) that performs weak hemolysis on cells and is likely to cause leukocyte aggregation is used. Therefore, in this embodiment, the blood sample is retested by using a leukocyte differential channel (DIFF channel) that performs strong hemolysis on cells and is not affected by aggregation, so that an accurate leukocyte count result can be obtained.
- DIFF channel leukocyte differential channel
- the retest instruction may be outputting the test result of the optical method.
- the above shows examples in which the controller 120 determines the abnormality type of the first test blood sample based on the sample image, and generates, based on the abnormality type, the instruction that causes the hematology analyzer 110 to perform the retest under the test condition corresponding to the abnormality type of the blood sample.
- the controller 120 may be a central controller that may be further configured to: obtain the sample image from the sample image capturing apparatus 150, analyze the sample image, and generate the retest instruction and send the retest instruction to one hematology analyzer 110 (said hematology analyzer may be the hematology analyzer for performing the initial test or may be another one different from it), so that said hematology analyzer performs the retest, when it is determined, based on the analysis, that the sample image contains information indicating that the first test blood sample is an abnormal sample.
- the controller 120 may be integrated into the sample image capturing apparatus 150, and the controller 120 may be further configured to: obtain the sample image, analyze the sample image, and generate the retest instruction and send the retest instruction to one hematology analyzer 110 (said hematology analyzer may be the hematology analyzer for performing the initial test or may be another one different from it), so that said hematology analyzer performs the retest, when it is determined, based on the analysis, that the sample image contains information indicating that the first test blood sample is an abnormal sample.
- the controller 120 may be integrated into one hematology analyzer 110 (said hematology analyzer may be the hematology analyzer for performing the initial test or may be another one different from it), and the controller 120 may be further configured to: obtain the sample image from the sample image capturing apparatus 150, analyze the sample image, and generate the retest instruction to control said hematology analyzer 110 (said hematology analyzer may be the hematology analyzer for performing the initial test or may be another one different from it) to perform the retest, when it is determined, based on the analysis, that the sample image contains information indicating that the first test blood sample is an abnormal sample.
- the controller 120 may be integrated into the sample slide preparation apparatus 140, and the controller 120 may be further configured to: obtain the sample image, analyze the sample image, and generate the retest instruction and send the retest instruction to the hematology analyzer 110 (said hematology analyzer may be the hematology analyzer for performing the initial test or may be another one different from it), so that said hematology analyzer performs the retest, when it is determined, based on the analysis, that the sample image contains information indicating that the first test blood sample is an abnormal sample.
- the controller 120 may include at least: a processing component, a random access memory (RAM), a read-only memory (ROM), a communication interface, a memory, and an output/input (I/O) interface, wherein the processing component, the RAM, the ROM, the communication interface, the memory, and the I/O interface communicate through a bus.
- the processing component may be a central processing unit (CPU), a graphics processing unit (GPU), or other chips with computing capabilities.
- An operating system, and various computer programs such as an application program executable by the processing component, and data required for execution of the computer programs are stored in the memory.
- any data that needs to be stored locally may be stored in the memory.
- the I/O interface is composed of a serial interface such as a USB, IEEE1394 or RS-232C, a parallel interface such as an SCSI, IDE or IEEE1284, and an analog signal interface composed of a D/A converter, A/D converter, and the like.
- An input device composed of a keyboard, a mouse, a touchscreen, or other control buttons is connected to the I/O interface, and a user may directly input data to a control device by using the input apparatus.
- the I/O interface may be further connected to a display with a display function, for example: a liquid crystal display, a touchscreen, an LED display, etc., and the control device may output the processed data as image display data to the display for displaying, for example, analysis data and an instrument operating parameter.
- the communication interface may be an interface which supports any currently known communication protocol.
- the communication interface communicates with the outside over a network.
- the controller 120 may transmit data with any device connected over the network through the communication interface and based on a communication protocol.
- the sample analysis system 100 is exemplarily described above. Based on the above description, according to the sample analysis system 100 in this the embodiment of the disclosure, the hematology analyzer first performs the initial test on the blood sample of the subject, the sample image capturing apparatus captures the sample image when the initial test result satisfies the preset condition, and generates the retest instruction when the sample image contains information indicating that the sample is an abnormal sample, such that the hematology analyzer retests the blood sample of the subject according to the instruction.
- the operation of the hematology analyzer can be controlled based on the sample image and because the sample image of the abnormal sample contains abnormal sample information, the hematology analyzer can be controlled to perform a specific retest operation based on the abnormal sample information, and a more accurate test result can thus be obtained.
- FIG. 11 is a schematic flowchart of a sample analysis system 1100 according to another embodiment of the disclosure.
- the sample analysis system 1100 includes a sample image capturing apparatus 1110, a controller 1120, and a hematology analyzer 1130.
- the sample image capturing apparatus 1110 is configured to capture a sample image of a sample region on a sample slide, the sample slide being prepared from a first test blood sample of a subject.
- the controller 1120 is configured to generate a test instruction and send the test instruction to the hematology analyzer 1130, so that the hematology analyzer 1130 analyzes a second test blood sample of the subject, when the sample image contains information indicating that the first test blood sample is an abnormal sample.
- the hematology analyzer 1130 is configured to analyze the second test blood sample, so as to obtain a sample analysis result.
- the sample analysis system 1100 according to this embodiment of the disclosure is similar to the sample analysis system 100 according to the embodiment of the disclosure described above in that the operation of the hematology analyzer is controlled based on the sample image, and a difference therebetween lies in that, according to the sample analysis system 100 in the embodiment of the disclosure described above, a hematology analyzer performs an initial test on the blood sample before the operation of the hematology analyzer is controlled based on the sample image, while according to the sample analysis system 1100 in this embodiment of the disclosure, the hematology analyzer is controlled to perform an initial test directly based on the sample image.
- the test instruction is generated when the sample image of the blood sample contains information indicating that the sample is an abnormal sample, such that the hematology analyzer tests the blood sample of the subject according to the instruction.
- the operation of the hematology analyzer can be controlled based on the sample image; and because the sample image of the abnormal sample contains abnormal sample information, the hematology analyzer can be controlled to perform a specific test operation based on the abnormal sample information, and an accurate test result can thus be obtained.
- the controller 1120 in the sample analysis system 1100 may be further configured to: determine an abnormality type of the first test blood sample based on the sample image, and generate the test instruction based on the abnormality type, wherein the test instruction includes an instruction that causes the hematology analyzer 1130 to perform analysis under a test condition corresponding to the abnormality type.
- the hematology analyzer performs the test under the test condition corresponding to the abnormality type of the blood sample, and can implement the test in a targeted manner, thereby outputting an accurate test result.
- the controller 1120 in the sample analysis system 1100 may be further configured to generate the instruction that causes the hematology analyzer 1130 to analyze the second test blood sample by using an optical method, when it is determined, based on the sample image, that the first test blood sample is at least one of a sample having a low platelet value, a sample having platelet aggregation, a sample having erythrocyte fragments, a sample having leukocyte fragments, a sample having microcytes, and a sample having large platelets.
- the controller 1120 in the sample analysis system 1100 may be further configured to generate the instruction that causes the hematology analyzer 1130 to treat the second test blood sample with a platelet disaggregation reagent, when it is determined, based on the sample image, that the first test blood sample is a sample having a low platelet value or a sample having platelet aggregation.
- the controller 1120 in the sample analysis system 1100 may be further configured to generate the instruction that causes the hematology analyzer 1130 to analyze erythrocytes in the second test blood sample by using an optical method, when it is determined, based on the sample image, that the first test blood sample is a sample having erythrocyte aggregation; generate the instruction that causes the hematology analyzer 1130 to analyze hemoglobin in the second test blood sample by using an optical method, when it is determined, based on the sample image, that the first test blood sample is a sample having a falsely elevated hemoglobin; and generate the instruction that causes the hematology analyzer 1130 to count leukocytes in the second test blood sample by using a leukocyte differential channel, when it is determined, based on the sample image, that the first test blood sample is a sample having leukocyte aggregation.
- the controller 1120 in the sample analysis system 1100 may be a central controller that may be further configured to: obtain the sample image from the sample image capturing apparatus 1110, analyze the sample image, and generate the test instruction and send the test instruction to the hematology analyzer 1130, so that the hematology analyzer 1130 performs the analysis, when it is determined, based on the analysis, that the sample image contains information indicating that the first test blood sample is an abnormal sample.
- the controller 1120 may be integrated into the sample image capturing apparatus 1110, and the controller 1120 is further configured to: obtain the sample image, analyze the sample image, and generate the test instruction and send the test instruction to the hematology analyzer 1130, so that the hematology analyzer 1130 performs the analysis, when it is determined, based on the analysis, that the sample image contains information indicating that the first test blood sample is an abnormal sample.
- the controller 1120 may be integrated into the hematology analyzer 1130, and the controller 1120 may be further configured to: obtain the sample image from the sample image capturing apparatus 1110, analyze the sample image, and generate the test instruction to control the hematology analyzer 1130 to perform the analysis, when it is determined, based on the analysis, that the sample image contains information indicating that the first test blood sample is an abnormal sample.
- the test instruction is generated when the sample image of the blood sample contains information indicating that the sample is an abnormal sample, such that the hematology analyzer tests the blood sample of the same subject according to the instruction.
- the operation of the hematology analyzer can be controlled based on the sample image; and because the sample image of the abnormal sample contains abnormal sample information, the hematology analyzer can be controlled to perform a specific test operation based on the abnormal sample information, and an accurate test result can thus be obtained.
- a sample analysis method is further provided.
- the sample analysis method may be performed by the sample analysis system 100 or the sample analysis system 1100 described above and will be described below with reference to FIGS. 12 and 13 .
- FIG. 12 is a schematic flowchart of a sample analysis method 1200 according to an embodiment of the disclosure. As shown in FIG. 12 , the sample analysis method 1200 may include the following steps:
- the sample analysis method 1200 according to this embodiment of the disclosure may be performed by the sample analysis system 100 according to the embodiment of the disclosure described above.
- Those skilled in the art can understand the detailed process of the sample analysis method 1200 according to this embodiment of the disclosure in conjunction with the above description, and for ease of brevity, only some main operations will be described herein, and details will not be repeated.
- the method 1200 may further include the following steps (not shown): determining an abnormality type of the first test blood sample based on the sample image, and generating the retest instruction based on the abnormality type, wherein the retest instruction includes an instruction that causes the hematology analyzer to perform a retest under a test condition corresponding to the abnormality type.
- generating a retest instruction based on the abnormality type may include: generating the retest instruction that causes the hematology analyzer to analyze the second test blood sample by using an optical method, when it is determined, based on the sample image, that the first test blood sample is at least one of a sample having a low platelet value, a sample having platelet aggregation, a sample having erythrocyte fragments, a sample having leukocyte fragments, a sample having microcytes, and a sample having large platelets; and/or generating the retest instruction that causes the hematology analyzer to treat the second test blood sample with a platelet disaggregation reagent, when it is determined, based on the sample image, that the first test blood sample is a sample having a low platelet value or a sample having platelet aggregation.
- generating a retest instruction based on the abnormality type may include at least one of the following: generating the retest instruction that causes the hematology analyzer to analyze erythrocytes in the second test blood sample by using an optical method, when it is determined, based on the sample image, that the first test blood sample is a sample having erythrocyte aggregation; generating the retest instruction that causes the hematology analyzer to analyze hemoglobin in the second test blood sample by using an optical method, when it is determined, based on the sample image, that the first test blood sample is a sample having a falsely elevated hemoglobin; and generating the retest instruction that causes the hematology analyzer to count leukocytes in the second test blood sample by using a leukocyte differential channel, when it is determined, based on the sample image, that the first test blood sample is a sample having leukocyte aggregation.
- the analysis on the first test blood sample is performed under a first test condition
- the retest on the second test blood sample is performed under a second test condition corresponding to the retest instruction
- the second test condition is different from the first test condition
- an initial test result of the blood sample of the subject is first obtained, the sample image of the blood sample is captured when the initial test result satisfies the preset condition, and the retest instruction is generated when the sample image contains information indicating that the sample is an abnormal sample, such that the hematology analyzer retests the blood sample of the same subject according to the instruction.
- the operation of the hematology analyzer can be controlled based on the sample image; and because the sample image of the abnormal sample contains abnormal sample information, the hematology analyzer can be controlled to perform a specific retest operation based on the abnormal sample information, and a more accurate test result can thus be obtained.
- FIG. 13 is a schematic flowchart of a sample analysis method 1300 according to another embodiment of the disclosure. As shown in FIG. 13 , the sample analysis method 1300 may include the following steps:
- sample analysis method 1300 may be performed by the sample analysis system 1100 according to the embodiment of the disclosure described above.
- Those skilled in the art can understand the detailed process of the sample analysis method 1300 according to this embodiment of the disclosure in conjunction with the above description, and for ease of brevity, only some main operations will be described herein, and details will not be repeated.
- the method 1300 may further include the following steps (not shown): determining an abnormality type of the first test blood sample based on the sample image, and generating the test instruction based on the abnormality type, wherein the test instruction includes an instruction that causes the hematology analyzer to perform analysis under a test condition corresponding to the abnormality type.
- generating a test instruction based on the abnormality type may further include: generating the instruction that causes the hematology analyzer to analyze the second test blood sample by using an optical method, when it is determined, based on the sample image, that the first test blood sample is at least one of a sample having a low platelet value, a sample having platelet aggregation, a sample having erythrocyte fragments, a sample having leukocyte fragments, a sample having microcytes, and a sample having large platelets; and/or generating the instruction that causes the hematology analyzer to treat the second test blood sample with a platelet disaggregation reagent, when it is determined, based on the sample image, that the first test blood sample is a sample having a low platelet value or a sample having platelet aggregation.
- generating a test instruction based on the abnormality type may further include at least one of the following: generating the instruction that causes the hematology analyzer to analyze erythrocytes in the second test blood sample by using an optical method, when it is determined, based on the sample image, that the first test blood sample is a sample having erythrocyte aggregation; generating the instruction that causes the hematology analyzer to analyze hemoglobin in the second test blood sample by using an optical method, when it is determined, based on the sample image, that the first test blood sample is a sample having a falsely elevated hemoglobin; and generating the test instruction that causes the hematology analyzer to count leukocytes in the second test blood sample by using a leukocyte differential channel, when it is determined, based on the sample image, that the first test blood sample is a sample having leukocyte aggregation.
- the test instruction is generated when the sample image of the blood sample contains information indicating that the sample is an abnormal sample, such that the hematology analyzer tests the blood sample of the same subject according to the instruction.
- the operation of the hematology analyzer can be controlled based on the sample image; and because the sample image of the abnormal sample contains abnormal sample information, the hematology analyzer can be controlled to perform a specific test operation based on the abnormal sample information, and an accurate test result can thus be obtained.
- a sample image analysis system may implement the functions of the sample image capturing apparatus and the controller in each of the sample analysis systems 100 and 1100 according to the above embodiments, and will be described below with reference to FIG. 14 .
- FIG. 14 is a schematic block diagram of a structure of a sample image analysis system 1400 according to an embodiment of the disclosure.
- the sample image analysis system 1400 may include a sample image capturing apparatus 1410 and a controller 1420, wherein the sample image capturing apparatus 1410 is configured to capture a sample image of a sample region on a sample slide prepared from a first test blood sample of a subject; and the controller 1420 is configured to analyze the sample image, and generate an instruction that causes a hematology analyzer to test a second test blood sample of the subject, when it is determined, based on the cell image, that the first test blood sample is an abnormal sample.
- the controller 1420 in the sample image analysis system 1400 may be further configured to: determine an abnormality type of the first test blood sample based on the sample image, and generate a test instruction based on the abnormality type, wherein the test instruction includes an instruction that causes the hematology analyzer to perform analysis under a test condition corresponding to the abnormality type.
- the controller 1420 in the sample image analysis system 1400 may be further configured to: generate the instruction that causes the hematology analyzer to analyze the second test blood sample by using an optical method, when it is determined, based on the sample image, that the first test blood sample is at least one of a sample having a low platelet value, a sample having platelet aggregation, a sample having erythrocyte fragments, a sample having leukocyte fragments, a sample having microcytes, and a sample having large platelets; and/or generate the instruction that causes the hematology analyzer to treat the second test blood sample with a platelet disaggregation reagent, when it is determined, based on the sample image, that the first test blood sample is a sample having a low platelet value or a sample having platelet aggregation.
- the controller 1420 in the sample image analysis system 1400 may be further configured to perform at least one of the following: generating the instruction that causes the hematology analyzer to analyze erythrocytes in the second test blood sample by using an optical method, when it is determined, based on the sample image, that the first test blood sample is a sample having erythrocyte aggregation; generating the instruction that causes the hematology analyzer to analyze hemoglobin in the second test blood sample by using an optical method, when it is determined, based on the sample image, that the first test blood sample is a sample having falsely elevated hemoglobin; and generating the instruction that causes the hematology analyzer to count leukocytes in the second test blood sample by using a leukocyte differential channel, when it is determined, based on the sample image, that the first test blood sample is a sample having leukocyte aggregation.
- the test instruction is generated when the sample image of the blood sample contains information indicating that the sample is an abnormal sample, such that the hematology analyzer tests the blood sample of the same subject according to the instruction.
- the operation of the hematology analyzer can be controlled based on the sample image; and because the sample image of the abnormal sample contains abnormal sample information, the hematology analyzer can be controlled to perform a specific test operation based on the abnormal sample information, and an accurate test result can thus be obtained.
- a hematology analyzer is further provided.
- the hematology analyzer may implement the functions of the hematology analyzer in the sample analysis system 100 according to the above embodiment, and will be described below with reference to FIG. 15 .
- FIG. 15 is a schematic block diagram of a structure of a hematology analyzer 1500 according to an embodiment of the disclosure.
- the hematology analyzer 1500 may include a sampling apparatus 1510, a sample preparation apparatus 1520, a test apparatus 1530, and a controller 1540, wherein the controller 1540 is configured to receive retest information associated with a sample slide that is sent by a sample image capturing apparatus or an instrument communicatively connected to the sample image capturing apparatus, and control the sampling apparatus 1510, the sample preparation apparatus 1520, and the test apparatus 1530 to analyze a second test blood sample of a subject based on the received retest information, the sample slide being prepared from a first test blood sample of the subject;
- the sampling apparatus 1510 is configured to sample the second test blood sample from a sample container;
- the sample preparation apparatus 1520 is configured to mix the second test blood sample and a reagent to prepare a blood sample solution;
- the test apparatus 1530 is configured to test the blood sample solution to obtain a blood routine test parameter
- the retest information received by the controller 1540 may include a sample image obtained by capturing the sample slide by the sample image capturing apparatus.
- the controller 1540 may be further configured to: determine an abnormality type of the first test blood sample based on the sample image, and generate a retest instruction based on the abnormality type, wherein the retest instruction includes an instruction that causes the sample preparation apparatus 1520 and the test apparatus 1530 to perform a retest under a test condition corresponding to the abnormality type.
- the retest information received by the controller 1540 may include a retest instruction generated based on the abnormality type of the first test blood sample, which is determined based on the sample image, wherein the sample image is obtained by capturing the sample slide by the sample image capturing apparatus; and the retest instruction may include an instruction that causes the sample preparation apparatus 1520 and the test apparatus 1530 to perform a retest under a test condition corresponding to the abnormality type.
- the controller 1540 may directly control the sample preparation apparatus 1520 and the test apparatus 1530 to perform corresponding operations based on the received instruction.
- the retest instruction may include: the retest instruction being an instruction that causes the sample preparation apparatus 1520 and the test apparatus 1530 to analyze the second test blood sample by using an optical method, when it is determined, based on the sample image, that the first test blood sample is at least one of a sample having a low platelet value, a sample having platelet aggregation, a sample having erythrocyte fragments, a sample having leukocyte fragments, a sample having microcytes, and a sample having large platelets; and/or the retest instruction being an instruction that causes the sample preparation apparatus 1520 to treat the second test blood sample with a platelet disaggregation reagent, and then the test apparatus 1530 to perform analysis, when it is determined, based on the sample image, that the first test blood sample is a sample having a low platelet value or a sample having platelet aggregation.
- the retest instruction may include at least one of the following: the retest instruction being an instruction that causes the sample preparation apparatus 1520 and the test apparatus 1530 to analyze erythrocytes in the second test blood sample by using an optical method, when it is determined, based on the sample image, that the first test blood sample is a sample having erythrocyte aggregation; the retest instruction being an instruction that causes the sample preparation apparatus 1520 and the test apparatus 1530 to analyze hemoglobin in the second test blood sample by using an optical method, when it is determined, based on the sample image, that the first test blood sample is a sample having a falsely elevated hemoglobin; and the retest instruction being an instruction that causes the sample preparation apparatus 1520 and the test apparatus 1530 to count leukocytes in the second test blood sample by using a leukocyte differential channel, when it is determined, based on the sample image, that the first test blood sample is a sample having leukocyte aggregation.
- the sampling apparatus 1510 has a pipette (for example, a sampling needle) with a pipette nozzle, and has a driving portion.
- the driving portion is configured to drive the pipette to quantitatively aspirate the test blood sample through the pipette nozzle.
- the sampling needle moves under the driving of the driving portion to aspirate the test blood sample from a sample container containing the blood sample.
- the sample preparation apparatus 1520 has at least one reaction cell and a reagent supply apparatus.
- the at least one reaction cell is configured to receive the test blood sample that is aspirated by the sampling apparatus 1510, and the reagent supply apparatus supplies the treatment reagent to the at least one reaction cell, so that the test blood sample that is aspirated by the sampling apparatus 1510 is mixed with the treatment reagent supplied by the reagent supply apparatus in the reaction cell so as to prepare a sample solution to be tested.
- the test apparatus 1530 is configured to test the sample solution to be tested that is prepared by the sample preparation apparatus 1520, so as to obtain a blood routine test parameter.
- the operations of the sampling apparatus, the sample preparation apparatus, and the test apparatus included in the hematology analyzer are controlled based on the retest information (the sample image or the retest instruction generated after analyzing the sample image) associated with the sample slide and received from the sample image capturing apparatus or an instrument communicatively connected to the sample image capturing apparatus, so that the operation of the hematology analyzer is controlled based on the sample image; and because the sample image of the abnormal sample contains abnormal sample information, the hematology analyzer can be controlled to perform a specific test operation based on the abnormal sample information, and an accurate test result can thus be obtained.
- the retest information the sample image or the retest instruction generated after analyzing the sample image
- a storage medium is further provided.
- the storage medium has program instructions stored therein, and the program instructions, when executed by a computer or processor, implement the corresponding steps of the sample analysis methods of the embodiments of the disclosure.
- the storage medium may include, for example, a memory card of a smart phone, a storage component of a tablet computer, a hard disk of a personal computer, a read-only memory (ROM), an erasable programmable read-only memory (EPROM), a portable compact disk read-only memory (CD-ROM), a USB memory, or any combination of the above storage media.
- the computer-readable storage medium may be any combination of one or more computer-readable storage media.
- a computer program is further provided.
- the computer program may be stored in a cloud or a local storage medium.
- the computer program when executed by a computer or processor, is used to implement the corresponding steps of the sample analysis methods according to the embodiments of the disclosure.
- the retest or test instruction is generated when the sample image of the blood sample contains the information indicating that the sample is an abnormal sample, such that the hematology analyzer retests or tests the blood sample of the same subject according to the instruction.
- the operation of the hematology analyzer can be controlled based on the sample image; and because the sample image of the abnormal sample contains abnormal sample information, the hematology analyzer can be controlled to perform a specific retest or test operation based on the abnormal sample information, and a more accurate test result can thus be obtained.
- the disclosed apparatuses and methods may be implemented in other ways.
- the apparatus embodiments described above are merely examples.
- the division of units is only a logic function division.
- there may be other division methods for example, a plurality of units or components may be combined or integrated into another apparatus, or some features may be omitted or not implemented.
- components in the disclosure may be implemented in hardware, or implemented by software modules running on one or more processors, or implemented in a combination thereof. It should be understood for those skilled in the art that a microprocessor or a digital signal processor (DSP) may be used in practice to implement some or all of the functions of some modules according to this embodiment of the disclosure.
- DSP digital signal processor
- the disclosure may further be implemented as a device program (e.g., a computer program and a computer program product) for executing some or all of the methods described herein.
- a program for implementing the disclosure may be stored on a computer-readable medium, or may be in the form of one or more signals. Such a signal may be downloaded from an Internet website, or provided on a carrier signal, or provided in any other form.
Landscapes
- Chemical & Material Sciences (AREA)
- Biochemistry (AREA)
- General Physics & Mathematics (AREA)
- Health & Medical Sciences (AREA)
- Life Sciences & Earth Sciences (AREA)
- Analytical Chemistry (AREA)
- Pathology (AREA)
- General Health & Medical Sciences (AREA)
- Physics & Mathematics (AREA)
- Immunology (AREA)
- Dispersion Chemistry (AREA)
- Engineering & Computer Science (AREA)
- Signal Processing (AREA)
- Quality & Reliability (AREA)
- Investigating Or Analysing Biological Materials (AREA)
Applications Claiming Priority (1)
| Application Number | Priority Date | Filing Date | Title |
|---|---|---|---|
| PCT/CN2020/133691 WO2022116112A1 (zh) | 2020-12-03 | 2020-12-03 | 样本分析系统、方法、样本图像分析系统及血液分析仪 |
Publications (4)
| Publication Number | Publication Date |
|---|---|
| EP4257984A1 true EP4257984A1 (de) | 2023-10-11 |
| EP4257984A4 EP4257984A4 (de) | 2024-01-17 |
| EP4257984C0 EP4257984C0 (de) | 2025-07-23 |
| EP4257984B1 EP4257984B1 (de) | 2025-07-23 |
Family
ID=81852819
Family Applications (1)
| Application Number | Title | Priority Date | Filing Date |
|---|---|---|---|
| EP20963958.2A Active EP4257984B1 (de) | 2020-12-03 | 2020-12-03 | Probenanalysesystem und -verfahren, probenbildanalysesystem und blutanalysegerät |
Country Status (4)
| Country | Link |
|---|---|
| US (1) | US20230314296A1 (de) |
| EP (1) | EP4257984B1 (de) |
| CN (1) | CN116615653A (de) |
| WO (1) | WO2022116112A1 (de) |
Families Citing this family (1)
| Publication number | Priority date | Publication date | Assignee | Title |
|---|---|---|---|---|
| CN117607479B (zh) * | 2023-11-30 | 2025-03-07 | 中元汇吉生物技术股份有限公司 | 样本处理方法、装置、样本分析仪及存储介质 |
Family Cites Families (10)
| Publication number | Priority date | Publication date | Assignee | Title |
|---|---|---|---|---|
| JPH0652263B2 (ja) * | 1985-12-10 | 1994-07-06 | 株式会社日立製作所 | 細胞分析装置 |
| JP5380026B2 (ja) * | 2008-09-24 | 2014-01-08 | シスメックス株式会社 | 標本撮像装置 |
| JP5301232B2 (ja) * | 2008-09-30 | 2013-09-25 | シスメックス株式会社 | 血球画像表示装置、検体分析システム、血球画像表示方法、及びコンピュータプログラム |
| JP5378859B2 (ja) * | 2009-03-30 | 2013-12-25 | シスメックス株式会社 | 検体検査システム |
| JP5372734B2 (ja) * | 2009-12-28 | 2013-12-18 | シスメックス株式会社 | 検体処理システム及び検体搬送ユニット |
| JP2011174844A (ja) * | 2010-02-25 | 2011-09-08 | Sysmex Corp | 臨床検査情報管理装置、臨床検査情報管理システム、及びコンピュータプログラム |
| EP3408640B1 (de) * | 2016-01-28 | 2021-01-06 | Siemens Healthcare Diagnostics Inc. | Verfahren und vorrichtung zur identifizierung eines probenbehälters aus mehreren seitlichen ansichten |
| CN109596852B (zh) * | 2017-09-30 | 2022-06-14 | 爱威科技股份有限公司 | 样本分析装置、样本检测设备及样本检测方法 |
| CN108333178A (zh) * | 2018-02-07 | 2018-07-27 | 爱威科技股份有限公司 | 临床标本分析方法及临床标本分析仪 |
| CN111856045A (zh) * | 2019-04-26 | 2020-10-30 | 北京深迈瑞医疗电子技术研究院有限公司 | 样本复检方法及样本分析仪 |
-
2020
- 2020-12-03 CN CN202080107637.4A patent/CN116615653A/zh active Pending
- 2020-12-03 WO PCT/CN2020/133691 patent/WO2022116112A1/zh not_active Ceased
- 2020-12-03 EP EP20963958.2A patent/EP4257984B1/de active Active
-
2023
- 2023-06-05 US US18/205,925 patent/US20230314296A1/en active Pending
Also Published As
| Publication number | Publication date |
|---|---|
| EP4257984A4 (de) | 2024-01-17 |
| US20230314296A1 (en) | 2023-10-05 |
| EP4257984C0 (de) | 2025-07-23 |
| WO2022116112A1 (zh) | 2022-06-09 |
| CN116615653A (zh) | 2023-08-18 |
| EP4257984B1 (de) | 2025-07-23 |
Similar Documents
| Publication | Publication Date | Title |
|---|---|---|
| US11402370B2 (en) | Alarming method for platelet aggregation sample, blood cell analyzer and storage medium | |
| JP5636381B2 (ja) | 細胞集団識別のための機器間の方法およびシステム | |
| CN111542744B (zh) | 血液分析仪、血液分析方法和计算机可读存储介质 | |
| US9005916B2 (en) | Blood cell analyzer, blood cell analyzing method, and non-transitory storage medium | |
| US8808623B2 (en) | Diagnosis assisting system, diagnosis assisting information providing device and computer program product | |
| US9618363B2 (en) | Specimen analysis system, specimen analyzer, and specimen analysis method | |
| US12216040B2 (en) | Sample analyzer and sample analysis method | |
| EP2566974B1 (de) | Diagnoseinstrument und fliessverfahren | |
| WO2005008254A1 (ja) | 臨床検査分析装置、臨床検査分析方法およびその方法をコンピュータに実行させるプログラム | |
| CN105980852A (zh) | 细胞分析方法和系统、装置 | |
| CN118311241A (zh) | 一种血液分析仪及样本处理方法 | |
| US20230314296A1 (en) | Sample testing method and sample analyzer | |
| EP4010682B1 (de) | Nachweis und bericht von subpopulationen von neutrophilen | |
| JPH04151541A (ja) | 細胞分析装置 | |
| US20220334099A1 (en) | Blood analysis apparatus, blood analysis method, and storage medium | |
| CN114615923A (zh) | 一种血液细胞检测结果处理方法、系统及存储介质 | |
| JP2021516335A (ja) | 生体細胞を含む生体試料の分析方法及びその分析方法を実施する分析装置 | |
| CN113884690B (zh) | 样本分析仪及其荧光试剂余量不足的判断方法 | |
| CN112798799B (zh) | 一种样本分析系统及样本测试方法 | |
| CN114563586A (zh) | 血液分析仪及其异常检测方法、计算机可读存储介质 | |
| CN116026728A (zh) | 血液分析仪及血液分析方法 | |
| EP4174488A1 (de) | Probenanalysevorrichtung und probenanalyseverfahren | |
| US20240344961A1 (en) | Sample analysis apparatus and sample analysis method | |
| CN112345777B (zh) | 样本分析装置、系统和质控失控后病人样本的管理方法 | |
| JP2024095228A5 (de) |
Legal Events
| Date | Code | Title | Description |
|---|---|---|---|
| STAA | Information on the status of an ep patent application or granted ep patent |
Free format text: STATUS: THE INTERNATIONAL PUBLICATION HAS BEEN MADE |
|
| PUAI | Public reference made under article 153(3) epc to a published international application that has entered the european phase |
Free format text: ORIGINAL CODE: 0009012 |
|
| STAA | Information on the status of an ep patent application or granted ep patent |
Free format text: STATUS: REQUEST FOR EXAMINATION WAS MADE |
|
| 17P | Request for examination filed |
Effective date: 20230629 |
|
| AK | Designated contracting states |
Kind code of ref document: A1 Designated state(s): AL AT BE BG CH CY CZ DE DK EE ES FI FR GB GR HR HU IE IS IT LI LT LU LV MC MK MT NL NO PL PT RO RS SE SI SK SM TR |
|
| A4 | Supplementary search report drawn up and despatched |
Effective date: 20231215 |
|
| RIC1 | Information provided on ipc code assigned before grant |
Ipc: G01N 15/10 20060101ALI20231211BHEP Ipc: G01N 15/14 20060101ALI20231211BHEP Ipc: G01N 33/50 20060101ALI20231211BHEP Ipc: G01N 35/00 20060101AFI20231211BHEP |
|
| DAV | Request for validation of the european patent (deleted) | ||
| DAX | Request for extension of the european patent (deleted) | ||
| GRAP | Despatch of communication of intention to grant a patent |
Free format text: ORIGINAL CODE: EPIDOSNIGR1 |
|
| STAA | Information on the status of an ep patent application or granted ep patent |
Free format text: STATUS: GRANT OF PATENT IS INTENDED |
|
| RIC1 | Information provided on ipc code assigned before grant |
Ipc: G01N 15/1433 20240101ALI20250204BHEP Ipc: G01N 15/1429 20240101ALI20250204BHEP Ipc: G01N 15/10 20060101ALI20250204BHEP Ipc: G01N 15/14 20060101ALI20250204BHEP Ipc: G01N 33/50 20060101ALI20250204BHEP Ipc: G01N 35/00 20060101AFI20250204BHEP |
|
| INTG | Intention to grant announced |
Effective date: 20250213 |
|
| GRAS | Grant fee paid |
Free format text: ORIGINAL CODE: EPIDOSNIGR3 |
|
| GRAA | (expected) grant |
Free format text: ORIGINAL CODE: 0009210 |
|
| STAA | Information on the status of an ep patent application or granted ep patent |
Free format text: STATUS: THE PATENT HAS BEEN GRANTED |
|
| AK | Designated contracting states |
Kind code of ref document: B1 Designated state(s): AL AT BE BG CH CY CZ DE DK EE ES FI FR GB GR HR HU IE IS IT LI LT LU LV MC MK MT NL NO PL PT RO RS SE SI SK SM TR |
|
| REG | Reference to a national code |
Ref country code: GB Ref legal event code: FG4D |
|
| REG | Reference to a national code |
Ref country code: CH Ref legal event code: EP |
|
| REG | Reference to a national code |
Ref country code: IE Ref legal event code: FG4D |
|
| REG | Reference to a national code |
Ref country code: DE Ref legal event code: R096 Ref document number: 602020055280 Country of ref document: DE |
|
| U01 | Request for unitary effect filed |
Effective date: 20250723 |
|
| U07 | Unitary effect registered |
Designated state(s): AT BE BG DE DK EE FI FR IT LT LU LV MT NL PT RO SE SI Effective date: 20250730 |
|
| PG25 | Lapsed in a contracting state [announced via postgrant information from national office to epo] |
Ref country code: IS Free format text: LAPSE BECAUSE OF FAILURE TO SUBMIT A TRANSLATION OF THE DESCRIPTION OR TO PAY THE FEE WITHIN THE PRESCRIBED TIME-LIMIT Effective date: 20251123 |
|
| PG25 | Lapsed in a contracting state [announced via postgrant information from national office to epo] |
Ref country code: NO Free format text: LAPSE BECAUSE OF FAILURE TO SUBMIT A TRANSLATION OF THE DESCRIPTION OR TO PAY THE FEE WITHIN THE PRESCRIBED TIME-LIMIT Effective date: 20251023 |
|
| PG25 | Lapsed in a contracting state [announced via postgrant information from national office to epo] |
Ref country code: HR Free format text: LAPSE BECAUSE OF FAILURE TO SUBMIT A TRANSLATION OF THE DESCRIPTION OR TO PAY THE FEE WITHIN THE PRESCRIBED TIME-LIMIT Effective date: 20250723 |
|
| PG25 | Lapsed in a contracting state [announced via postgrant information from national office to epo] |
Ref country code: GR Free format text: LAPSE BECAUSE OF FAILURE TO SUBMIT A TRANSLATION OF THE DESCRIPTION OR TO PAY THE FEE WITHIN THE PRESCRIBED TIME-LIMIT Effective date: 20251024 |
|
| PG25 | Lapsed in a contracting state [announced via postgrant information from national office to epo] |
Ref country code: PL Free format text: LAPSE BECAUSE OF FAILURE TO SUBMIT A TRANSLATION OF THE DESCRIPTION OR TO PAY THE FEE WITHIN THE PRESCRIBED TIME-LIMIT Effective date: 20250723 |
|
| PG25 | Lapsed in a contracting state [announced via postgrant information from national office to epo] |
Ref country code: RS Free format text: LAPSE BECAUSE OF FAILURE TO SUBMIT A TRANSLATION OF THE DESCRIPTION OR TO PAY THE FEE WITHIN THE PRESCRIBED TIME-LIMIT Effective date: 20251023 |
|
| PG25 | Lapsed in a contracting state [announced via postgrant information from national office to epo] |
Ref country code: ES Free format text: LAPSE BECAUSE OF FAILURE TO SUBMIT A TRANSLATION OF THE DESCRIPTION OR TO PAY THE FEE WITHIN THE PRESCRIBED TIME-LIMIT Effective date: 20250723 |
|
| U20 | Renewal fee for the european patent with unitary effect paid |
Year of fee payment: 6 Effective date: 20251230 |